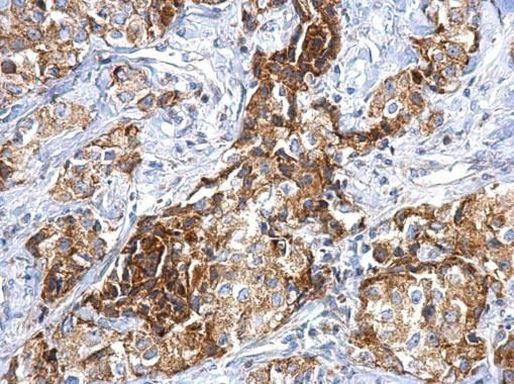
FGFR1 Antibody in Immunohistochemistry (Paraffin) (IHC (P))

Search
Invitrogen
FGFR1 Polyclonal Antibody
{{$productOrderCtrl.translations['antibody.pdp.commerceCard.promotion.promotions']}}
{{$productOrderCtrl.translations['antibody.pdp.commerceCard.promotion.viewpromo']}}
{{$productOrderCtrl.translations['antibody.pdp.commerceCard.promotion.promocode']}}: {{promo.promoCode}} {{promo.promoTitle}} {{promo.promoDescription}}. {{$productOrderCtrl.translations['antibody.pdp.commerceCard.promotion.learnmore']}}
产品信息
PA5-28564
宿主/亚型
分类
类型
抗原
偶联物
形式
浓度
规格
保存条件
运输条件
RRID
产品详细信息
PA5-28564 targets FGFR1 in IHC (P) and WB applications and shows reactivity with Human and mouse samples.
The PA5-28564 immunogen is recombinant protein fragment corresponding to a region within amino acids 1 and 820 of Human FGFR1.
靶标信息
FGFR1 (also known as FLT2) is a member of the Fibroblast Growth Factor Receptor family that constitute a family of four membrane-spanning tyrosine kinases (FGFR1-4) which serve as high-affinity receptors for 17 growth factors (FGF1-17). The FGF Receptor family plays an important role in multiple biological processes, including mesoderm induction and patterning, cell growth and migration, organ formation and bone growth. FGFR1 is alternatively spliced generating multiple splice variants that are differentially expressed during embryo development and in the adult body. Other defects in FGFR1 are responsible for several diseases which include Pfeiffer syndrome (PS), idiopathic hypogonadotropic hypogonadism (IHH), Kallmann syndrome type 2 (KAL2), osteoglophonic dysplasia (OGD), non-syndromic trigonocephaly, Jackson-Weiss syndrome, Antley-Bixler syndrome. Chromosomal aberrations involving this gene are associated with stem cell myeloproliferative disorder and stem cell leukemia lymphoma syndrome.
⚠WARNING: This product can expose you to chemicals including mercury, which is known to the State of California to cause birth defects or other reproductive harm. For more information go to www.P65Warnings.ca.gov.
仅用于科研。不用于诊断过程。未经明确授权不得转售。